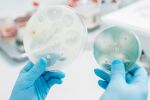
Инфекции, устойчиви на антибиотици, ще нараснат с 60% до 2030 г.

Нови данни от Великобритания и Европейския съюз установяват тревожна тенденция, бактериите стават все по-умни, а антибиотиците, все по-безпомощни.
В Обединеното кралство през 2024 година всяка седмица са регистрирани близо 400 нови случая на инфекции, причинени от антибиотично-резистентни бактерии.
Това е повече от една инфекция на всеки час, денонощно. Още по-притеснителни са данните за тежките кръвни инфекции – те са се увеличили с 9,3% само за една година, като броят на смъртните случаи е скочнал с 338 души.
Картината в Европейския съюз е не по-различна. Според последните данни на Европейския център за превенция и контрол на заболяванията, над 35 000 души годишно умират в Европа, като пряка последица от инфекции с антибиотично-резистентни бактерии. Икономическата цена? Приблизително 12 млрд евро годишно в разходи за здравеопазване и загуби в производителността.
Невидимият враг в нашата кръв
Най-опасните от тези инфекции са бактериалните, състояния, при които бактериите циркулират директно в кръвта. В Обединеното кралство 65% от всички резистентни кръвни инфекции през последните шест години са причинени от бактерията Escherichia coli, познатата ни E. coli, която обикновено се свързва с инфекции на пикочните пътища.
Проблемът е, че когато една бактерия стане резистентна към антибиотици, тя престава да реагира на лечение. Това води до сериозни усложнения, като сепсис, продължителна хоспитализация и значително по-висок риск от смърт. Хората с резистентни инфекции имат много по-голям шанс да починат в рамките на 30 дни, в сравнение с тези, чиито инфекции реагират на антибиотиците.
Особено тревожна е ситуацията в Европа с бактерията Klebsiella pneumoniae, резистентна към карбапенеми, група от най-силните антибиотици. Кръвните инфекции, причинени от този микроорганизъм, са се увеличили с почти 60% спрямо базовата 2019 година. Тази бактерия е резистентна към множество класове антибиотици и има изключително ограничени възможности за лечение.
Как стигнахме дотук?
Антибиотичната резистентност възниква естествено в природата , това е начинът, по който бактериите се адаптират, за да оцелеят. Но ние сме ускорили този процес драматично чрез начина, по който използваме антибиотиците.
В Обединеното кралство, макар употребата на антибиотици в Националната здравна служба да е намаляла, частните рецепти са се увеличили повече от два пъти между 2019 и 2024 година. Общо употребата на антибиотици в първичната медицинска помощ е нараснала с 10,7%, като вече 22% от всички антибиотици се отпускат чрез частния сектор.
В Европейския съюз ситуацията е подобна. Консумацията на антибиотици през 2023 година е нараснала с 1% спрямо 2019 година, въпреки резките спадове в началото на пандемията от COVID-19. Още по-притеснително е, че приблизително 83% от възрастните с вирусни инфекции на дихателните пътища като грип все още получават антибиотици, въпреки че тези лекарства нямат никакъв ефект върху вирусите.
Кой е най-уязвим?
Възрастните хора над 45 години представляват 90% от всички случаи на резистентни инфекции в Обединеното кралство, като почти половината от тях са на възраст над 74 години. Причината е, че с възрастта се увеличават медицинските състояния и експозицията към медицински интервенции, което повишава риска от инфекции.
Но може би най-тревожното откритие е социалното неравенство в тази здравна заплаха. В Обединеното кралство хората, живеещи в най-бедните общности, имат с 47,2% по-висок риск от резистентна кръвна инфекция в сравнение с тези в най-заможните райони. Още по-притеснително е, че този разрив се е разширил от 29% през 2019 година до 47% през 2024 година. Най-уязвимите в обществото понасят най-тежката тежест на тази криза.
Какво можем да направим?
Всеки от нас има роля в справянето с антибиотичната резистентност. Ето няколко практични стъпки:
- Приемайте антибиотици само когато е необходимо. Никога не настоявайте за антибиотици при вирусни инфекции като настинка или грип – те просто няма да помогнат. Доверете се на препоръките на вашия лекар.
- Не споделяйте и не пазете антибиотици. Ако ви са останали антибиотици от предишно лечение, занесете ги в аптека за правилно изхвърляне. Никога не ги давайте на приятели или семейство.
- Завършете пълния курс на лечение. Когато ви бъдат предписани антибиотици, приемайте ги точно както е указано, дори ако се почувствате по-добре. Преждевременното спиране може да позволи на оцелелите бактерии да развият резистентност.
- Ваксинирайте се. Ваксините предотвратяват инфекции още преди да се случат. Колкото по-малко инфекции имаме, толкова по-малко антибиотици ще трябва да използваме.
- Поддържайте добра хигиена. Редовното миене на ръцете и добрите хигиенни практики могат да предотвратят разпространението на бактерии, включително резистентни щамове.
Надпреварата с времето
Експертите предупреждават, че без по-решителни действия, броят на смъртните случаи в Европа, причинени от антибиотично-резистентни инфекции, може да достигне 90 000 годишно до 2050 година. Европейският съюз има амбициозни цели за намаляване на антибиотичната резистентност до 2030 година, но според последните данни, е малко вероятно ЕС да постигне всичките си цели относно антибиотичната резистентност без по-силни и по-бързи действия в областта на общественото здраве.
Професор Сюзан Хопкинс, изпълнителен директор на Агенцията за здравна сигурност на Обединеното кралство,коментира: "Антибиотичната резистентност е една от най-големите здравни заплахи, пред които сме изправени. Повече хора от всякога придобиват инфекции, които не могат да бъдат ефективно лекувани с антибиотици."
Решението изисква глобални усилия, от разработката на нови антибиотици и диагностични методи до по-добро наблюдение и превенция на инфекциите. Антибиотиците са едни от най-ценните инструменти на модерната медицина. Начинът, по който ги използваме днес, ще определи дали те ще продължат да спасяват животи и утре.
Съдържанието е информативно и не представлява консултация, препоръка или съвет. При въпроси относно вашето здраве, медицинско състояние или лечение, задължително се консултирайте с медицински специалист.